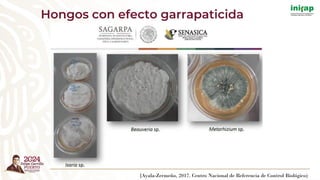
(Ayala-Zermeño, 2017. Centro Nacional de Referencia de Control Biológico)
Hongos con efecto garrapaticida

El documento describe un curso teórico-práctico sobre estrategias sustentables para la prevención y control de plagas agropecuarias, incluyendo métodos de control biológico y el uso de insectos entomófagos. Discute la importancia de los organismos vivos en la gestión de plagas y presenta casos exitosos de control, destacando el crecimiento de la industria de control biológico en México. Además, menciona alternativas como extractos y aceites esenciales para el manejo de insectos plaga.


































































































































































































































































































































![(Castro-Saines et al., 2021, Experimental and Applied Acarology)
[Proteína]
(µg/mL)
Mortalidad
(%)
I O (%) Control (%)
Testigo 0 a 0 a 0 a
1.25 42.22 ± 4.45 b 39.36 ± 1.87 bc 28.12 ± 5.10 b
2.5 44.44 ± 9.70 b 33.73 ± 7.50 bc 20.28 ± 10.95 b
5 46.66 ± 10.20 b 33.06 ± 1.78 bc 18.64 ± 6.30 b
10 55.55 ± 8.02 b 50.93 ± 4.49 c 52.53 ± 5.46 b
20 33.33 ± 6.67 b 26.44 ± 6.38 b 9.34 ± 16.64 b
40 42.22 ± 5.89 b 42.25 ± 4.63 bc 30.61 ± 14.87 b
Larvas Hembras adultas
Desafío con múltiples dosis. Mortalidad de larvas y hembras adultas de garrapata R. microplus
expuestas a diferentes concentraciones de proteína de S. marcescens.
Las barras indican el porcentaje de mortalidad promedio ± error estándar, diferente literal indica
diferencias significativas, Tukey (p<0.05).
Control microbiano: bacterias](https://image.slidesharecdn.com/materialdidcticocontrolplagas-241029215708-28a26569/85/Material-didactico-CONTROL-PLAGAS-pdf-323-320.jpg)